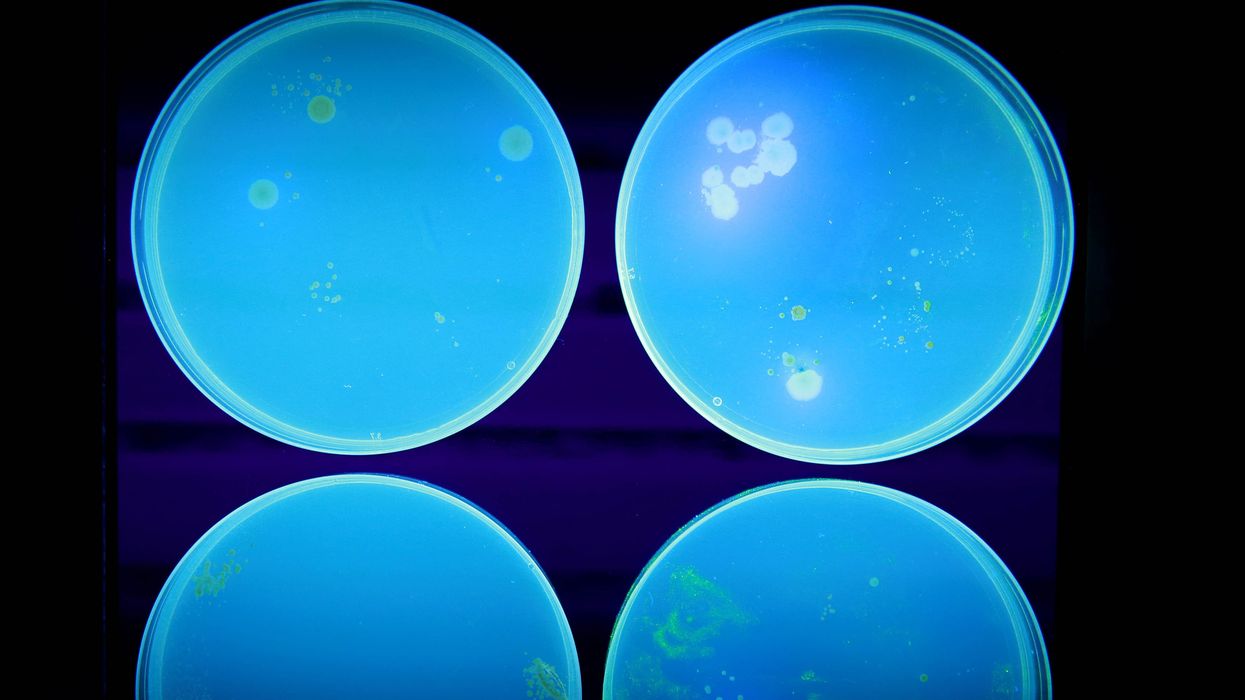

Cheese recall warning: One dead after E. coli outbreak across UK
Some 30 cases of E.Coli have been discovered in the UK
|PA

A person has died following an outbreak of E. coli
Don't Miss
Most Read
Latest
A person has died following an outbreak of E. coli in the UK, health officials said.
The UK Health Security Agency (UKHSA) said 30 confirmed cases of Shiga toxin-producing E. coli, (Stec) have been recorded across England and Scotland in patients aged seven to 81.
The agency added a person from Scotland had now died from the infection.
The Food Standards Agency (FSA) announced a precautionary recall of four products from cheesemaker Mrs Kirkham’s Lancashire Cheese on Christmas Eve because of possible E. coli contamination.
The UKHSA said investigations were continuing into any common links between cases, including links to the recalled cheeses.
More to follow...
How long is it safe to keep your Christmas food in the fridge for?
It’s all about your fridge
According to government food safety advice, cooked fish and meat can be kept in the fridge for three to four days, while dairy will depend more on what it is.
Cheese, for example, can be kept longer than cream and custard.
While there are general guidelines for most food groups, such as dairy, meat and seafood, “how long you can keep food in the fridge after Christmas will depend on several factors, including the temperature of your fridge, the freshness of your food before it is cooked and how it is stored,” explains GP Dr Babak Ashrafi at Asda Online Doctor.
“It is generally safe to keep food for a couple of days after Christmas, as long as it is refrigerated and stored properly. But use your best judgement before eating any leftovers, and be sure to throw away any food that doesn’t look or smell safe to eat."
The coldest part of the fridge should be under 5°C, according to the Food Standards Agency.
The risks
Taking a chance and eating meat that has been kept in a sub-standard fridge or has been held onto for too long could make you very unwell.
“Leaving meat at room temperature, or not refrigerating it at low enough temperatures, can encourage bacteria to grow and lead to foodborne illnesses,” says Ashrafi.
“Certain bacteria, such as Salmonella and E. coli, thrive on meat and can make you very sick. Food contaminated with these bacteria can lead to vomiting, diarrhoea, abdominal pain and, in very serious cases, require medical treatment.”
Don’t leave food out on the side – even for a buffet
Your Christmas food may spend a worrying number of cumulative hours going in and out of the fridge for picky lunches and buffets in the days following Christmas.
“The Food Standards Agency recommends not letting your food sit between 8°C and 63°C, as this is where bacteria thrive. Keeping your food out of the “danger zone” will prevent the bacteria in your food from multiplying and reduce your risk of contracting a foodborne illness,” Ashrafi explains.
As well as the temperature of your food, “it’s important to pay attention to use-by and sell-by dates, and look out for signs of spoilage. If your food smells off or doesn’t look right, err on the side of caution and throw it away – you don’t want to ruin your Christmas holiday with a bout of food poisoning.”
If you are worried about the date on something whose wrapper you threw away, or if something doesn’t smell quite right, it is worth avoiding the dangerous bacteria that could be rife on any of your Christmas leftovers.









